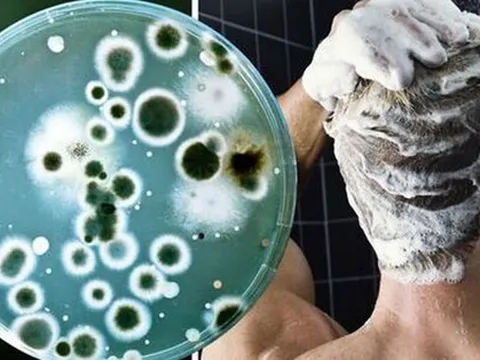
Bác sĩ cảnh báo: Không vệ sinh thứ này trong phòng tắm đúng cách có thể gây tổn thương da, phổi

Sức khỏe
Bộ Y tế chấn chỉnh cơ sở khám chữa bệnh để người dân bức xúc
Các cơ sở khám chữa bệnh cần rà soát, chấn chỉnh, giám sát việc thực hiện các quy định về Quy tắc ứng xử của công chức, viên chức, người lao động tại các cơ sở y tế.
Tẩy tóc khiến cả mảng da đầu cô gái trẻ loét, chảy mủ
Cô gái trẻ nhập viện với vết thương trên đầu đã lở loét, chảy mủ sau khi thực hiện tẩy tóc làm đẹp.
Loại quả ‘nặng mùi’ bị nhiều người chê nhưng là vị thuốc bổ, giảm mỡ máu, ngừa cả ung thư
Ít ai biết thứ quả bị nhiều người chê này lại có nhiều công dụng tốt với sức khỏe đến vậy.
Giật mình với “lò” đào tạo chuyên gia thẩm mỹ: Vài tháng vững tay nghề
Bất cứ ai cũng có thể học tiêm filler, sau vài tháng là có thể làm nghề… đây là những lời mời chào học viên của các “Học viện thẩm mỹ quốc tế”, “Trung tâm làm đẹp".
Suýt thiệt mạng vì khuyên răn nhầm... côn đồ
Ngày 27/8, thông tin từ Bệnh viện Chợ Rẫy (TPHCM) cho biết vừa cấp cứu thành công cho bệnh nhân T.Đ.T.D bị nhiều vết đâm, nhập viện trong tình trạng nguy kịch.
Tp.HCM: Giám đốc bệnh viện công tập huấn về luật đấu thầu
Ngày 27/8, lãnh đao Sở Y tế Tp.HCM cho biết, 85 giám đốc bệnh viện, trung tâm y tế công lập vừa tham gia buổi tập huấn liên quan các quy định về công tác đấu thầu.
Tp.HCM: Phòng khám Đa khoa Nam Việt bị xử phạt 200 triệu và đình chỉ hoạt động
Ngày 28/8, Thanh tra Sở Y tế Tp.HCM vừa ra quyết định xử vi phạm hành chính đối với Phòng khám Đa khoa Nam Việt 200 triệu đồng và đình chỉ hoạt động.
Dịch đau mắt đỏ gia tăng và những điều cần lưu ý
Thời gian gần đây, bệnh nhân đau mắt đỏ tại Hà Nội gia tăng mạnh. Chỉ trong 3 tuần đầu tháng 8, Bệnh viện Mắt Trung ương tiếp nhận hơn 2.500 bệnh nhân bị đau mắt đỏ đến khám. Con số này cao gấp đôi so với tháng 6.
Tại sao một số người “ăn cả thế giới” vẫn không thể béo?
Hóa ra đằng sau tình trạng ăn nhiều mà không béo có liên quan tới 5 nguyên nhân này.
Kiểu ăn khiến ung thư đại trực tràng ngày càng trẻ hóa, nhiều người mắc phải mà không biết
Tỷ lệ mắc ung thư đại trực tràng ở người trẻ dưới 50 tuổi đang có xu hướng gia tăng nhanh chóng. Các nhà nghiên cứu cho rằng chế độ ăn uống kém lành mạnh là nguyên nhân chính của sự gia tăng này.
Khẩn trương điều tra nguyên nhân nghi uống nước nhiễm thuốc trừ cỏ tại Điện Biên
Liên quan đến vụ hàng chục người dân bản Co Pục, xã Hua Thanh, huyện Điện Biên phải nhập viện cấp cứu nghi ngộ độc do uống nước nhiễm thuốc trừ cỏ, Bí thư Tỉnh ủy Điện Biên – ông Trần Quốc Cường đã yêu cầu các cơ quan chức năng khẩn trương làm rõ nguyên nhân vụ việc.
Hoảng hồn khi thấy đoạn kim khí sắc nhọn mắc trong họng bé 8 tuổi
Mới đây, Trung tâm Y tế huyện Tân Sơn (Phú Thọ) vừa thực hiện thành công ca can thiệp lấy dị vật thực quản là đoạn kim khí hình chữ U ra khỏi thực quản bé gái 8 tuổi.
Bác sĩ cảnh báo: Không vệ sinh thứ này trong phòng tắm đúng cách có thể gây tổn thương da, phổi
Bác sĩ cảnh báo, việc giữ phòng tắm sạch sẽ có ý nghĩa vô cùng quan trọng với sức khỏe của bạn.
Vụ đầu độc khiến 4 mẹ con tử vong: Khí CO nguy hiểm thế nào?
Cacbon monoxit (khí CO) được gọi là kẻ giết người thầm lặng, loại khí này thường gây ra những cái chết “êm ái” không báo trước.